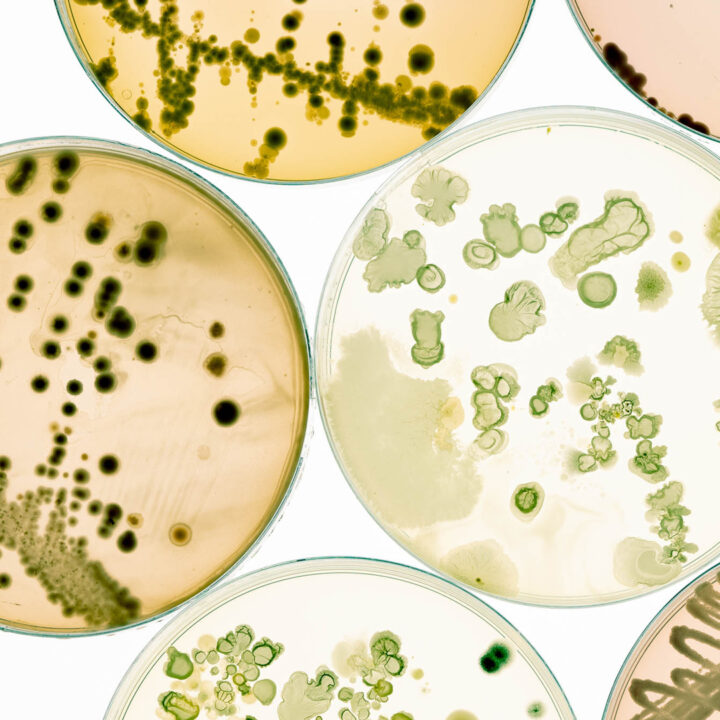

IT
Viele der Fälle in unserer Praxis beziehen sich auf Software im Bereich der Netzwerk- und Steuerungsanlagen, sei es unter dem Aspekt der computerimplementierten Erfindungen oder des Urheberrechts.
Verbundene Fälle
- Data Scape ./. Riverbed (Netzwerkleistung in WANs)
- Intel ./. Via (Chipsätze)
- Kieback & Peter ./. NXT Control (Schneider Electric-Tochter) (Open-Source-Elemente in programmiertem Quellcode)
- Samsung Electronics ./. Ericsson (Chip-Design)
- Sick ./. Wieland Electric (Steuersoftware)
- TeleTan ./. Sparda-Bank West (Transaktionssicherheitssystem)